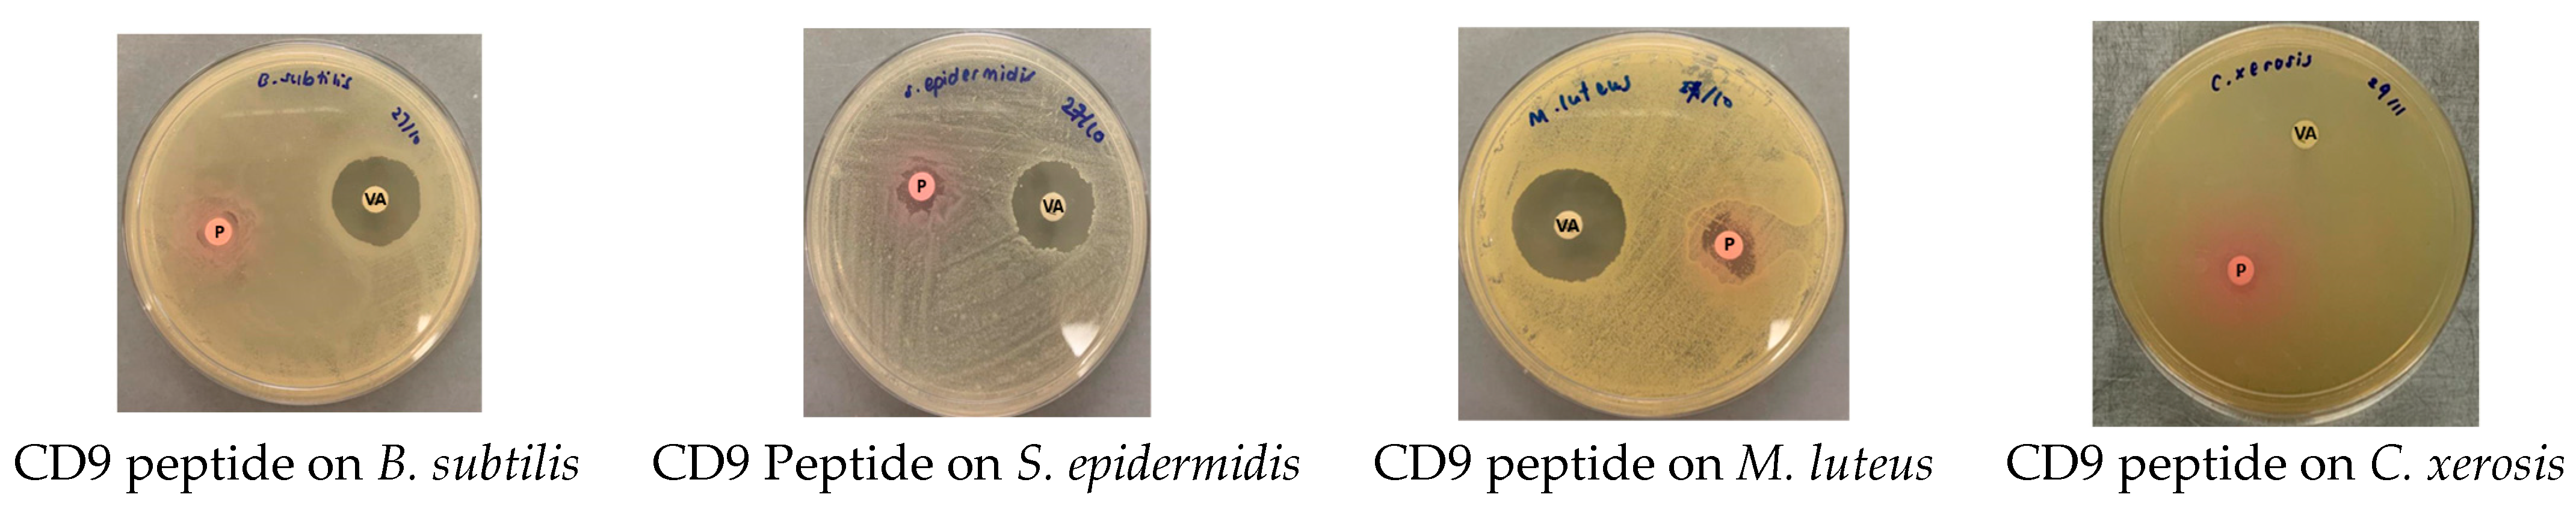
Antibiotics 12 00271 g001

Antimicrobial Effects of Tetraspanin CD9 Peptide against Microbiota Causing Armpit Malodour
Abstract
1. Introduction
2. Results
3. Discussion
4. Materials and Methods
4.1. Bacterial Strains
4.2. CD9 Tetraspanin Peptide
4.3. Antimicrobial Susceptibility of Tetraspanin CD9 Peptide against Armpit Bacterial Flora
4.4. Minimal Inhibitory Concentration (MIC)
4.5. Minimal Bactericidal Concentration (MBC)
4.6. Bacterial Biofilm Inhibition by CD9 Tetraspanin Peptide
4.7. Statistical Analysis
5. Conclusions
Author Contributions
Funding
Institutional Review Board Statement
Informed Consent Statement
Data Availability Statement
Acknowledgments
Conflicts of Interest
References
- Natsch, A.; Emter, R. The specific biochemistry of human axilla odour formation viewed in an evolutionary context. Philos. Trans. R. Soc. Lond. B Biol. Sci. 2020, 375, 20190269. [Google Scholar] [CrossRef]
- Callewaert, C.; Lambert, J.; Van de Wiele, T. Towards a bacterial treatment for armpit malodour. Exp. Dermatol. 2017, 26, 388–391. [Google Scholar] [CrossRef] [PubMed]
- Al-Talib, H.I.; Mohd Nasir, N.I.S.; Yaziz, H.; Zulkafli, N.F.; Adani, N.A.; Noor Rashidi, A.I.; Murugaiah, C.; Shaari, S.A. Potassium Aluminium Sulphate (Alum) Inhibits Growth of Human Axillary Malodor-Producing Skin Flora in Vitro. J. Clin. Health Sci. 2016, 1, 59–63. [Google Scholar] [CrossRef]
- Bovell, D. The human eccrine sweat gland: Structure, function and disorders. J. Local Glob. Health Sci. 2015, 5, 2–16. [Google Scholar] [CrossRef]
- Minhas, G.S.; Bawdon, D.; Herman, R.; Rudden, M.; Stone, A.P.; James, A.G.; Thomas, G.H.; Newstead, S. Structural basis of malodour precursor transport in the human axilla. Elife 2018, 7, e34995. [Google Scholar] [CrossRef] [PubMed]
- Roberts, M. New Generation of Deodorants ‘on the Way’. Available online: https://www.bbc.com/news/health-44680255 (accessed on 14 January 2023).
- Pariser, D.M.; Ballard, A. Topical therapies in hyperhidrosis care. Derm. Clin. 2014, 32, 485–490. [Google Scholar] [CrossRef] [PubMed]
- Murad, K.; Ab Rahim, S.; Al-Talib, H. Antimicrobial Effects of Tetraspanins: A New Turnabout in Treatment of Microorganisms. Malays. J. Med. Sci. 2022, 29, 6–13. [Google Scholar] [CrossRef] [PubMed]
- Ventress, J.K.; Partridge, L.J.; Read, R.C.; Cozens, D.; MacNeil, S.; Monk, P.N. Peptides from Tetraspanin CD9 Are Potent Inhibitors of Staphylococcus Aureus Adherence to Keratinocytes. PLoS ONE 2016, 11, e0160387. [Google Scholar] [CrossRef]
- Kummer, D.; Steinbacher, T.; Schwietzer, M.F.; Tholmann, S.; Ebnet, K. Tetraspanins: Integrating cell surface receptors to functional microdomains in homeostasis and disease. Med. Microbiol. Immunol. 2020, 209, 397–405. [Google Scholar] [CrossRef] [PubMed]
- Zumaquero, E.; Munoz, P.; Cobo, M.; Lucena, G.; Pavon, E.J.; Martin, A.; Navarro, P.; Garcia-Perez, A.; Ariza-Veguillas, A.; Malavasi, F.; et al. Exosomes from human lymphoblastoid B cells express enzymatically active CD38 that is associated with signaling complexes containing CD81, Hsc-70 and Lyn. Exp. Cell Res. 2010, 316, 2692–2706. [Google Scholar] [CrossRef]
- van Spriel, A.B.; Figdor, C.G. The role of tetraspanins in the pathogenesis of infectious diseases. Microbes Infect. 2010, 12, 106–112. [Google Scholar] [CrossRef] [PubMed]
- Lorico, A.; Lorico-Rappa, M.; Karbanova, J.; Corbeil, D.; Pizzorno, G. CD9, a tetraspanin target for cancer therapy? Exp. Biol. Med. 2021, 246, 1121–1138. [Google Scholar] [CrossRef]
- Alrahimi, J. The Role of Tetraspanins in Pseudomonas aeruginosa Adherence to Human Cells; University of Sheffield: Sheffield, UK, 2018. [Google Scholar]
- Oliveira, E.C.V.; Salvador, D.S.; Holsback, V.; Shultz, J.D.; Michniak-Kohn, B.B.; Leonardi, G.R. Deodorants and antiperspirants: Identification of new strategies and perspectives to prevent and control malodor and sweat of the body. Int. J. Dermatol. 2021, 60, 613–619. [Google Scholar] [CrossRef] [PubMed]
- Dornic, N.; Ficheux, A.S.; Roudot, A.C. Consumption of cosmetic products by the French population. Third part: Product exposure amount. Food. Chem. Toxicol. 2017, 106, 209–222. [Google Scholar] [CrossRef] [PubMed]
- Bhatt, H.; Patel, N.B. Natural Deodorants: A way towards sustainable cosmetics. Int. J. Pharm. Sci. Health Care 2021, 3, 1–6. [Google Scholar] [CrossRef]
- Maya, S.; Prakash, T.; Madhu, K.D.; Goli, D. Multifaceted effects of aluminium in neurodegenerative diseases: A review. Biomed. Pharm. 2016, 83, 746–754. [Google Scholar] [CrossRef] [PubMed]
- Qin, Z.; Zhang, J.; Xu, B.; Chen, L.; Wu, Y.; Yang, X.; Shen, X.; Molin, S.; Danchin, A.; Jiang, H.; et al. Structure-based discovery of inhibitors of the YycG histidine kinase: New chemical leads to combat Staphylococcus epidermidis infections. BMC Microbiol. 2006, 6, 96. [Google Scholar] [CrossRef] [PubMed]
- Healthcare, G. Synthetic Peptides are Promising Therapeutic Candidates for COVID-19. Available online: https://www.pharmaceutical-technology.com/comment/synthetic-peptides-covid-19-candidates/ (accessed on 14 January 2023).
- Wang, L.; Wang, N.; Zhang, W.; Cheng, X.; Yan, Z.; Shao, G.; Wang, X.; Wang, R.; Fu, C. Therapeutic peptides: Current applications and future directions. Signal Transduct. Target. Ther. 2022, 7, 48. [Google Scholar] [CrossRef] [PubMed]
- Rima, M.; Rima, M.; Fajloun, Z.; Sabatier, J.M.; Bechinger, B.; Naas, T. Antimicrobial Peptides: A Potent Alternative to Antibiotics. Antibiotics 2021, 10, 1095. [Google Scholar] [CrossRef] [PubMed]
- Fiedler, G.; Schneider, C.; Igbinosa, E.O.; Kabisch, J.; Brinks, E.; Becker, B.; Stoll, D.A.; Cho, G.S.; Huch, M.; Franz, C. Antibiotics resistance and toxin profiles of Bacillus cereus-group isolates from fresh vegetables from German retail markets. BMC Microbiol. 2019, 19, 250. [Google Scholar] [CrossRef]
- Stein, T. Bacillus subtilis antibiotics: Structures, syntheses and specific functions. Mol. Microbiol. 2005, 56, 845–857. [Google Scholar] [CrossRef] [PubMed]
- Caulier, S.; Gillis, A.; Colau, G.; Licciardi, F.; Liepin, M.; Desoignies, N.; Modrie, P.; Legreve, A.; Mahillon, J.; Bragard, C. Versatile Antagonistic Activities of Soil-Borne Bacillus spp. and Pseudomonas spp. against Phytophthora infestans and Other Potato Pathogens. Front. Microbiol. 2018, 9, 143. [Google Scholar] [CrossRef] [PubMed]
- Yu, G.; Baeder, D.Y.; Regoes, R.R.; Rolff, J. Predicting drug resistance evolution: Insights from antimicrobial peptides and antibiotics. Proc. Biol. Sci. 2018, 285, 20172687. [Google Scholar] [CrossRef]
- Batt, C.A.; Tortorello, M.L. Encyclopedia of Food Microbiology, 2nd ed.; Elsevier: Alpharetta, GA, USA, 2014. [Google Scholar]
- Chabi, R.; Momtaz, H. Virulence factors and antibiotic resistance properties of the Staphylococcus epidermidis strains isolated from hospital infections in Ahvaz, Iran. Trop. Med. Health 2019, 47, 56. [Google Scholar] [CrossRef] [PubMed]
- Liebl, W.; Kloos, W.E.; Ludwig, W. Plasmid-borne macrolide resistance in Micrococcus luteus. Microbiol 2002, 148, 2479–2487. [Google Scholar] [CrossRef]
- Offret, C.; Fliss, I.; Bazinet, L.; Marette, A.; Beaulieu, L. Identification of A Novel Antibacterial Peptide from Atlantic Mackerel belonging to the GAPDH-Related Antimicrobial Family and Its In Vitro Digestibility. Mar. Drugs. 2019, 17, 413. [Google Scholar] [CrossRef]
- De Mandal, S.; Panda, A.K.; Murugan, C.; Xu, X.; Senthil Kumar, N.; Jin, F. Antimicrobial Peptides: Novel Source and Biological Function With a Special Focus on Entomopathogenic Nematode/Bacterium Symbiotic Complex. Front. Microbiol. 2021, 12, 555022. [Google Scholar] [CrossRef]
- Charles, M.D.; Lui, L.-P. Antimicrobial Peptides. Australia Patent WO2003000277A3, 1 May 2003. [Google Scholar]
- Hahne, J.; Kloster, T.; Rathmann, S.; Weber, M.; Lipski, A. Isolation and characterization of Corynebacterium spp. from bulk tank raw cow’s milk of different dairy farms in Germany. PLoS ONE 2018, 13, e0194365. [Google Scholar] [CrossRef]
- Funari, R.; Shen, A.Q. Detection and Characterization of Bacterial Biofilms and Biofilm-Based Sensors. ACS Sens. 2022, 7, 347–357. [Google Scholar] [CrossRef]
- Shahrooei, M.; Hira, V.; Stijlemans, B.; Merckx, R.; Hermans, P.W.; Van Eldere, J. Inhibition of Staphylococcus epidermidis biofilm formation by rabbit polyclonal antibodies against the SesC protein. Infect. Immun. 2009, 77, 3670–3678. [Google Scholar] [CrossRef]
- Chen, S.P.; Chen, E.H.; Yang, S.Y.; Kuo, P.S.; Jan, H.M.; Yang, T.C.; Hsieh, M.Y.; Lee, K.T.; Lin, C.H.; Chen, R.P. A Systematic Study of the Stability, Safety, and Efficacy of the de novo Designed Antimicrobial Peptide PepD2 and Its Modified Derivatives Against Acinetobacter baumannii. Front. Microbiol. 2021, 12, 678330. [Google Scholar] [CrossRef] [PubMed]
- Lam, T.H.; Verzotto, D.; Brahma, P.; Ng, A.H.Q.; Hu, P.; Schnell, D.; Tiesman, J.; Kong, R.; Ton, T.M.U.; Li, J.; et al. Understanding the microbial basis of body odor in pre-pubescent children and teenagers. Microbiome 2018, 6, 213. [Google Scholar] [CrossRef] [PubMed]

| B. subtilis | S. epidermidis | M. luteus | C. xerosis | |
|---|---|---|---|---|
| Inhibition Zones (mm) of Three Replicates ± SD | ||||
| CD9 peptide (1 mg/mL) | 6.00 ± 0 | 7.67 ± 2.89 | 9.67 ± 4.04 | 7.00 ± 2.00 |
| Vancomycin (30 μg) | 19.67 ± 1.53 | 19.33 ± 0.58 | 24.33 ± 0.58 | 24.75 ± 20.84 |
| Armpit Bacterial Flora | MBC (mg/mL) | MIC (mg/mL) |
|---|---|---|
| S. epidermidis | 1 | 0.5 |
| B. subtilis | 1 | 0.125 |
| M. luteus | 1 | 0.5 |
| C. xerosis | 1 | 0.25 |
| Samples | Untreated (without CD9 Peptides) | Treated (with CD9 Peptides) | % Inhibition | p-Value |
|---|---|---|---|---|
| Mean ± SD Absorbance Reading OD 595 nm | ||||
| S. epidermidis | 0.120 ± 0.004 | 0.065 ± 0.003 | 45.8 | <0.05 |
| B. subtilis | 0.090 ± 0.003 | 0.062 ± 0.003 | 31.11 | <0.05 |
| M. luteus | 0.073 ± 0.002 | 0.080 ± 0.012 | −9.59 | n.a |
| C. xerosis | 0.083 ± 0.002 | 0.061 ± 0.004 | 26.51 | <0.05 |
| LB (control) | 0.071 ± 0.004 | 0.068 ± 0.001 | n.a | |
| GA (control) | 0.055 ± 0.001 | 0.055 ± 0.001 | n.a | |
Disclaimer/Publisher’s Note: The statements, opinions and data contained in all publications are solely those of the individual author(s) and contributor(s) and not of MDPI and/or the editor(s). MDPI and/or the editor(s) disclaim responsibility for any injury to people or property resulting from any ideas, methods, instructions or products referred to in the content. |
© 2023 by the authors. Licensee MDPI, Basel, Switzerland. This article is an open access article distributed under the terms and conditions of the Creative Commons Attribution (CC BY) license (https://creativecommons.org/licenses/by/4.0/).
Share and Cite
Al-Talib, H.; Abdulwahab, M.H.; Murad, K.; Amiruddin, N.D.; Mohamed, N.N. Antimicrobial Effects of Tetraspanin CD9 Peptide against Microbiota Causing Armpit Malodour. Antibiotics 2023, 12, 271. https://doi.org/10.3390/antibiotics12020271
Al-Talib H, Abdulwahab MH, Murad K, Amiruddin ND, Mohamed NN. Antimicrobial Effects of Tetraspanin CD9 Peptide against Microbiota Causing Armpit Malodour. Antibiotics. 2023; 12(2):271. https://doi.org/10.3390/antibiotics12020271
Chicago/Turabian StyleAl-Talib, Hassanain, Marwa Hasan Abdulwahab, Khairiyah Murad, Nur Deanna Amiruddin, and Normi Ngah Mohamed. 2023. "Antimicrobial Effects of Tetraspanin CD9 Peptide against Microbiota Causing Armpit Malodour" Antibiotics 12, no. 2: 271. https://doi.org/10.3390/antibiotics12020271
APA StyleAl-Talib, H., Abdulwahab, M. H., Murad, K., Amiruddin, N. D., & Mohamed, N. N. (2023). Antimicrobial Effects of Tetraspanin CD9 Peptide against Microbiota Causing Armpit Malodour. Antibiotics, 12(2), 271. https://doi.org/10.3390/antibiotics12020271

